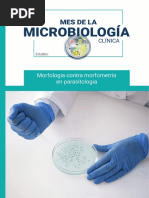

100% encontró este documento útil (1 voto)
360 vistas10 páginasPresentacion PxLAB
PxLAB es un sistema mexicano con más de 20 años de experiencia en laboratorios clínicos privados y de gobierno en México y América Latina. El sistema permite el registro y seguimiento de pacientes, muestras, resultados y facturación, así como la generación de reportes. Cuenta con interfases con equipos de diagnóstico y opciones para laboratorios centrales y sucursales. PxLAB sigue normas de calidad e incluye herramientas estadísticas para la planeación.
Cargado por
Marti Jimenez HernandezDerechos de autor
© © All Rights Reserved
Nos tomamos en serio los derechos de los contenidos. Si sospechas que se trata de tu contenido, reclámalo aquí.
Formatos disponibles
Descarga como PDF, TXT o lee en línea desde Scribd
100% encontró este documento útil (1 voto)
360 vistas10 páginasPresentacion PxLAB
PxLAB es un sistema mexicano con más de 20 años de experiencia en laboratorios clínicos privados y de gobierno en México y América Latina. El sistema permite el registro y seguimiento de pacientes, muestras, resultados y facturación, así como la generación de reportes. Cuenta con interfases con equipos de diagnóstico y opciones para laboratorios centrales y sucursales. PxLAB sigue normas de calidad e incluye herramientas estadísticas para la planeación.
Cargado por
Marti Jimenez HernandezDerechos de autor
© © All Rights Reserved
Nos tomamos en serio los derechos de los contenidos. Si sospechas que se trata de tu contenido, reclámalo aquí.
Formatos disponibles
Descarga como PDF, TXT o lee en línea desde Scribd